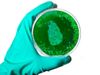
what is Aspergillosis green fungus cases In India Symptoms

पंजाब में ग्रीन फंगस का पहला केस, कोविड-19 से उबर चुके शख्स में दिखे लक्षण
पंजाब में ग्रीन फंगस का पहला केस दर्ज किया गया है। कोरोना वायरस संक्रमण से उबर चुके एक मरीज में ग्रीन फंगस का मामला देखा गया है। उसे तीन महीने पहले कोविड-19 का संक्रमण हुआ था।

- पंजाब में ग्रीन फंगस के पहले मामले की पुष्टि हुई है
- कोविड से उबर चुके मरीज को इसका संक्रमण हुआ है
- लगातार खांसी आने पर उसे अस्पताल में भर्ती कराया गया था
चंडीगढ़ : पंजाब में ग्रीन फंगस का पहला मामला सामने आया है। कोविड-19 से उबर चुके एक शख्स में इसकी पुष्टि हुई है। जलंधर के एक अस्पताल में उसका इलाज चल रहा है। उसे खांसी की शिकायत के बाद अस्पताल में भर्ती कराया गया था। मरीज को सांस लेने में तकलीफ, सीने में दर्द जैसी समस्याएं भी हो रही हैं। राज्य में हालांकि ग्रीन फंगस के मामलों को लेकर पहले भी रिपोर्ट आई थी, लेकिन इनकी पुष्टि नहीं हुई थी।
जलंधर जिला सिविल अस्पताल के महामारी विशेषज्ञ डॉ. परमवीर सिंह के मुताबिक, 'हमें ग्रीन फंगस के पहले मामले की पुष्टि की है। मरीज को पूर्व में कोविड-19 का संक्रमण हुआ था, लेकिन वह ठीक हो गए थे। फिलहाल उसे निगरानी में रखा गया है और यह नहीं कहा जा सकता कि हालत स्थिर है। पहले भी ऐसे ही एक मामले की जानकारी सामने आई थी, लेकिन उसकी पुष्टि नहीं हुई थी।'
खांसी के बाद कराया था भर्ती
रिपोर्ट्स के मुताबिक, अमृतसर के रय्या निवासी 62 वर्षीय व्यक्ति को खांसी की शिकायत बाद कुछ दिनों पहले सेक्रेड हार्ट अस्पताल में भर्ती कराया गया था। शनिवार को उनके ग्रीन फंगस से पीड़ित होने की पुष्टि हुई। जब उन्हें अस्पताल में भर्ती कराया गया तो डॉक्टरों को लगा कि उन्हें टीबी हो सकता है, लेकिन जांच में उनके ग्रीन फंगस से पीड़ित होने की पुष्टि हुई। डॉक्टर्स के लिए भी यह चौंकाने वाला है।
अस्पताल के एक डॉक्टर ने चिंता जताते हुए कहा, 'यह हमारे लिए चौंकाने वाला था। ब्लैक फंगस के बाद अब ग्रीन फंगस का संक्रमण चिंता की बात है।'
जिस शख्स में ग्रीन फंगस की पुष्टि हुई है, वह करीब तीन महीने पहले कोविड-19 की चपेट में आया था। लुधियाना के एक निजी अस्पताल में उसका इलाज चला था, जहां लंबे समय तक उन्हें ऑक्सीजन सपोर्ट पर रखा गया था। हालांकि कोविड-19 से उबरने के बाद उन्हें खांसी और अन्य जटिलताएं हुईं, जिसके बाद उन्हें जलंधर के एक अस्पताल में भर्ती कराया गया। मरीज में खांसी, सांस लेने में तकलीफ, सीने में दर्द जैसी समस्याएं देखी जा रही हैं।
Times Now Navbharat पर पढ़ें India News in Hindi, साथ ही ब्रेकिंग न्यूज और लाइव न्यूज अपडेट के लिए हमें गूगल न्यूज़ पर फॉलो करें ।